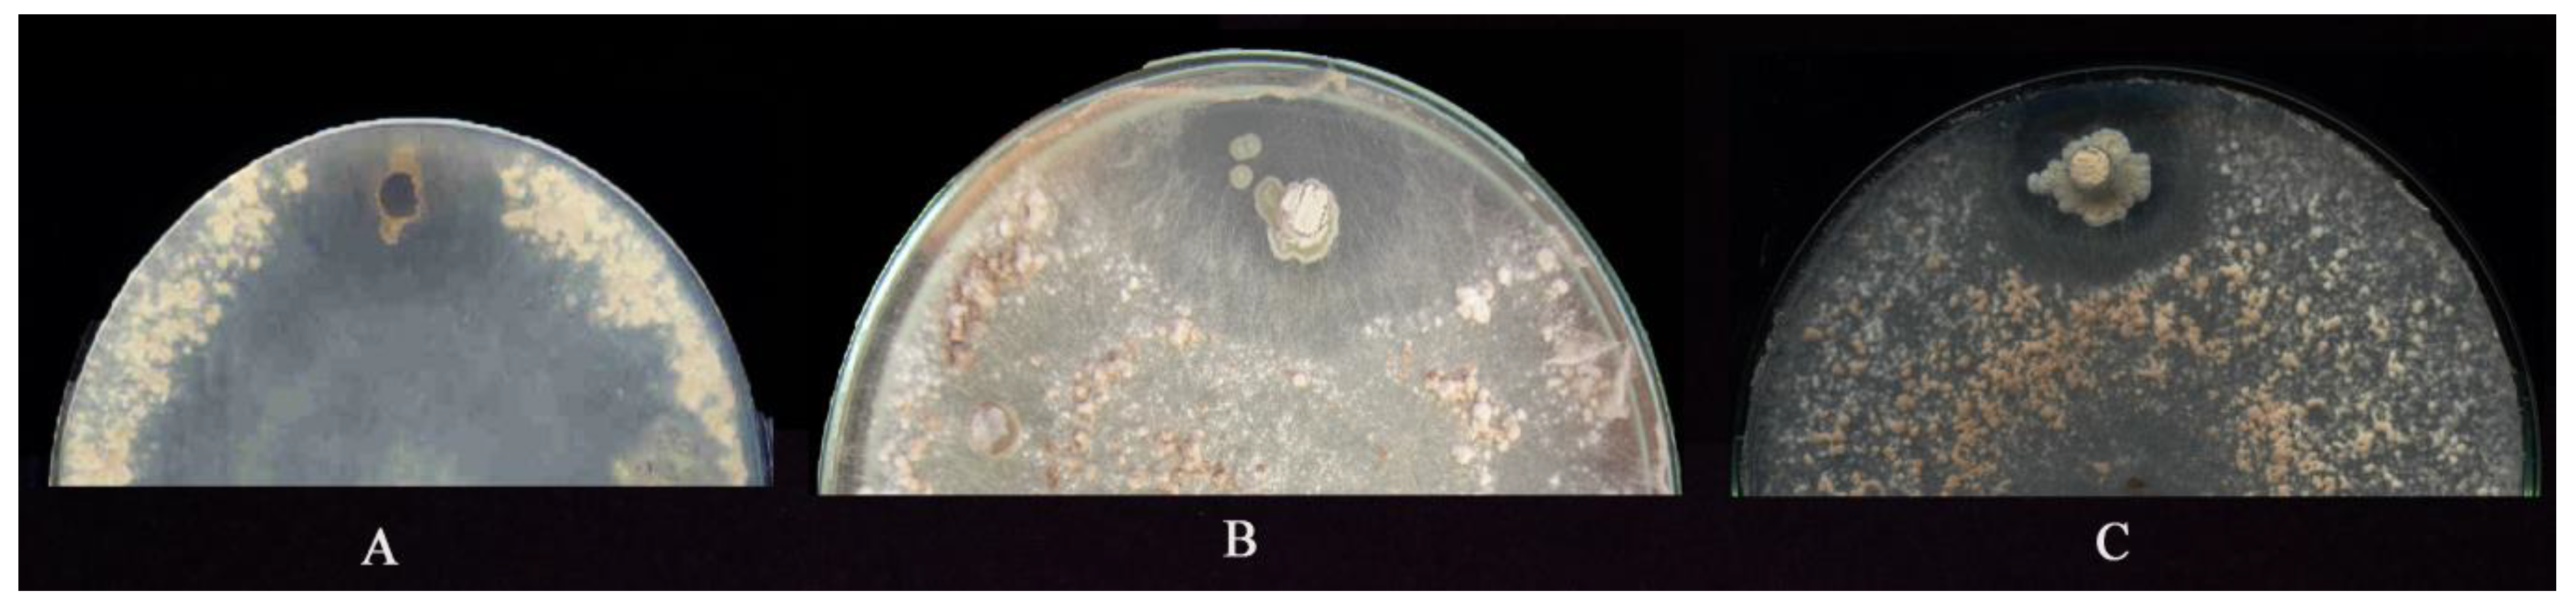
Agronomy 12 02292 g001 Agronomy 12 02292 g001
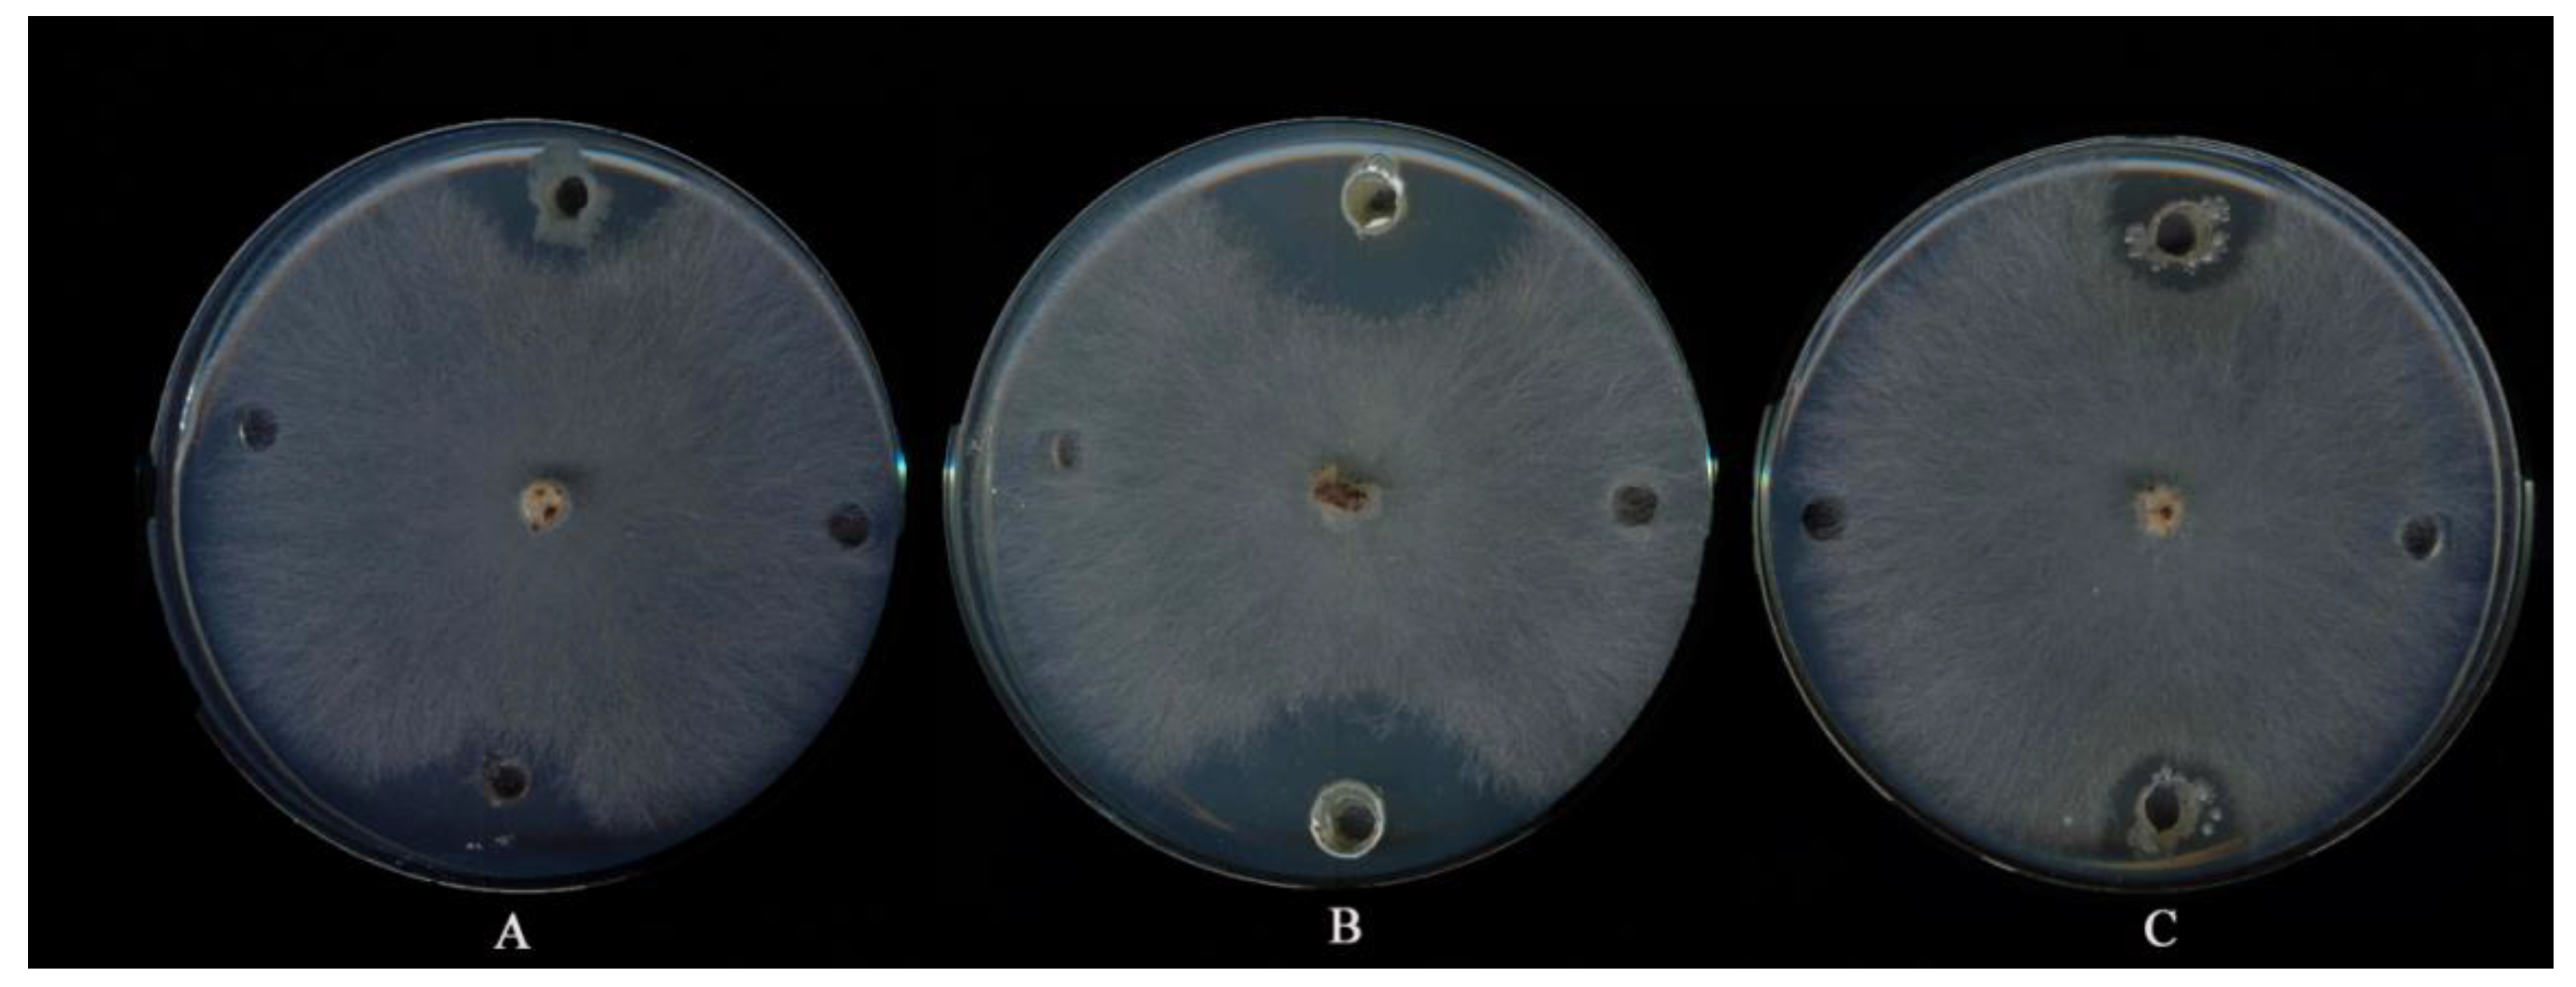
Agronomy 12 02292 g004 Agronomy 12 02292 g004

Investigating the Potential of Streptomyces spp. in Suppression of Rhizoctonia solani (AG1-IA) Causing Rice Sheath Blight Disease in Northern Iran
Abstract
1. Introduction
2. Materials and Methods
2.1. Seed Source, Rice Pathogen and Actinomycetes Isolation
2.2. In Vitro Screening, Antifungal Bioassays and Scanning Electron Microscopy (SEM)
2.3. Chloroform Sensitivity Assay of Bioactive Compounds
2.4. Monitoring Antifungal Activity in Submerged Cultures and Preparation of Crude Extract
2.5. Determination of Minimum Inhibitory Concentrations (MIC) and Thermal Inactivation Point (TIP)
2.6. Detection of Fungicidal and/or Fungistatic Activities
2.7. Production of Extracellular Lytic Enzymes (Proteases, Lipases, Amylases, and Chitinase)
2.8. Investigation of Inhibitory Effects of Antagonists on Mycelia and Sclerotia of Pathogen
2.9. In Vivo Experiments to Assess the Effects of Potential Antagonists on Rice Seedlings Growth
2.10. Morphological and Molecular Identifications of Potential Antagonists
2.11. In Vivo Examination of Potential Antagonists against Rhizoctonia Solani under Glasshouse Conditions
2.12. Statistical Analysis
3. Results
3.1. Isolation and SCREENING the Actinobacteria for Suppressiveness Activity
3.2. Chloroform Sensitivity Assay
3.3. Antifungal Properties of Submerged Cultures
3.4. Fungicidal and/or Fungistatic Properties of Antagonists
3.5. Minimum Inhibitory Concentration and Thermal Inactivation Point
3.6. Production of Extracellular Lytic Enzymes
3.7. Examination of Inhibitory Effects of Antagonists on Mycelia and Sclerotia of Fungus
3.8. Effect of Antagonistic Isolates on Rice Seedlings Grown in MS Media
3.9. Molecular Identification of Promising Antagonists and SEM Studies
3.10. Examination of Potential Antagonists against Rhizoctonia Solani under Glasshouse Condition
4. Discussion
5. Conclusions
Author Contributions
Funding
Data Availability Statement
Acknowledgments
Conflicts of Interest
References
- Ali, M.; Ahmad, A.; Sultana, S.; Mir, S.R. Chemical constituents from the seed husks of Oryza sativa L. Nat. Prod. Res. 2022, 1–9. [Google Scholar] [CrossRef] [PubMed]
- Li, S.; Shen, L.; Hu, P.; Liu, Q.; Zhu, X.; Qian, Q.; Wang, K.; Wang, Y. Developing disease-resistant thermo sensitive male sterile rice by multiplex gene editing. J. Integr. Plant Biol. 2019, 61, 1201–1205. [Google Scholar] [CrossRef] [PubMed]
- Boukaew, S.; Prasertsan, P. Suppression of rice sheath blight disease using a heat stable culture filtrate from Streptomyces philanthi RM-1-138. Crop Prot. 2014, 61, 1–10. [Google Scholar] [CrossRef]
- Yu, Y.-Y.; Jiang, C.-H.; Wang, C.; Chen, L.-J.; Li, H.-Y.; Xu, Q.; Guo, J.-H. An improved strategy for stable biocontrol agents selecting to control rice sheath blight caused by Rhizoctonia solani. Microbiol. Res. 2017, 203, 1–9. [Google Scholar] [CrossRef]
- Nookongbut, P.; Kantachote, D.; Khuong, N.Q.; Tantirungkij, M. The biocontrol potential of acid-resistant Rhodopseudomonas palustris KTSSR54 and its exopolymeric substances against rice fungal pathogens to enhance rice growth and yield. Biol. Control 2020, 150, 104354. [Google Scholar] [CrossRef]
- Daryaei, A.; Jones, E.E.; Alizadeh, H.; Glare, T.R.; Falloon, R.E. Biochemical characteristics of Trichoderma atroviride associated with conidium fitness for biological control. Biocontrol Sci. Technol. 2016, 26, 189–205. [Google Scholar] [CrossRef]
- Kumar, R.; Khatri, A.; Acharya, V. Deep learning uncovers distinct behavior of rice network to pathogens response. iScience 2022, 25, 104546. [Google Scholar] [CrossRef]
- Gnanamanickam, S. An Overview of Progress in Biological Control. In Biological Control of Rice Diseases; Progress in Biological Control; Springer: Amsterdam, The Netherlands, 2009; Volume 8, pp. 43–51. [Google Scholar] [CrossRef]
- Cuong, N.; Nicolaisen, M.; Sørensen, J.; Olsson, S. Hyphae-Colonizing Burkholderia sp. A New Source of Biological Control Agents Against Sheath Blight Disease (Rhizoctonia solani AG1-IA) in Rice. Microb. Ecol. 2011, 62, 425–434. [Google Scholar] [CrossRef]
- Boubekri, K.; Soumare, A.; Mardad, I.; Lyamlouli, K.; Ouhdouch, Y.; Hafidi, M.; Kouisni, L. Multifunctional role of Actinobacteria in agricultural production sustainability: A review. Microbiol. Res. 2022, 261, 127059. [Google Scholar] [CrossRef] [PubMed]
- Ebrahimi-Zarandi, M.; Saberi Riseh, R.; Tarkka, M.T. Actinobacteria as Effective Biocontrol Agents against Plant Pathogens, an Overview on Their Role in Eliciting Plant Defense. Microorganisms 2022, 10, 1739. [Google Scholar] [CrossRef]
- Chukwuneme, C.F.; Babalola, O.O.; Kutu, F.R.; Ojuederie, O.B. Characterization of Actinomycetes isolates for plant growth promoting traits and their effects on drought tolerance in maize. J. Plant Interact. 2020, 15, 93–105. [Google Scholar] [CrossRef]
- Cui, H.; Shaaban, K.; Schiebel, M.; Qin, S.; Laatsch, H. New antibiotic with typical plant anthraquinone structure obtained studying terrestrial and marine Streptomycetes. World J. Microbiol. Biotechnol. 2008, 24, 419–421. [Google Scholar] [CrossRef]
- Xu, Z.; Ji, L.; Tang, W.; Guo, L.; Gao, C.; Chen, X.; Liu, J.; Hu, G.; Liu, L. Metabolic engineering of Streptomyces to enhance the synthesis of valuable natural products. Eng. Microbiol. 2022, 2, 100022. [Google Scholar] [CrossRef]
- Minuto, A.; Spadaro, D.; Garibaldi, A.; Gullino, M.L. Control of soilborne pathogens of tomato using a commercial formulation of Streptomyces griseoviridis and solarization. Crop. Prot. 2006, 25, 468–475. [Google Scholar] [CrossRef]
- Kang, J.E.; Han, J.W.; Jeon, B.J.; Kim, B.S. Efficacies of quorum sensing inhibitors, piericidin A and glucopiericidin A, produced by Streptomyces xanthocidicus KPP01532 for the control of potato soft rot caused by Erwinia carotovora subsp. atroseptica. Microbiol. Res. 2016, 184, 32–41. [Google Scholar] [CrossRef] [PubMed]
- Rambabu, V.; Suba, S.; Vijayakumar, S. Antimicrobial and antiproliferative prospective of kosinostatin a secondary metabolite isolated from Streptomyces sp. J. Pharm. Anal. 2015, 5, 378–382. [Google Scholar] [CrossRef] [PubMed]
- Lyu, M.; Cheng, Y.; Han, X.; Wen, Y.; Song, Y.; Li, J.; Chen, Z. AccR, a TetR family transcriptional repressor, coordinates short-chain acyl coenzyme A homeostasis in Streptomyces avermitilis. Appl. Environ. Microbiol. 2020, 86, e00508–e00520. [Google Scholar] [CrossRef]
- John, K.N.; Valentin, V.; Abdullah, B.; Bayat, M.; Kargar, M.H.; Zargar, M. Weed mapping technologies in discerning and managing weed infestation levels of farming systems. Res. on Crops. 2020, 21, 93–98. [Google Scholar]
- Li, Q.; Jiang, Y.; Ning, P.; Zheng, L.; Huang, J.; Li, G.; Jiang, D.; Hsiang, T. Suppression of Magnaporthe oryzae by culture filtrates of Streptomyces globisporus JK-1. Biol. Control 2011, 58, 139–148. [Google Scholar] [CrossRef]
- Li, Q.; Ning, P.; Zheng, L.; Huang, J.; Li, G.; Hsiang, T. Effects of volatile substances of Streptomyces globisporus JK-1 on control of Botrytis cinerea on tomato fruit. Biol. Control 2012, 61, 113–120. [Google Scholar] [CrossRef]
- Prabavathy, V.R.; Mathivanan, N.; Murugesan, K. Control of blast and sheath blight diseases of rice using antifungal metabolites produced by Streptomyces sp. PM5. Biol. Control 2006, 39, 313–319. [Google Scholar] [CrossRef]
- Law, J.W.-F.; Ser, H.-L.; Khan, T.M.; Chuah, L.-H.; Pusparajah, P.; Chan, K.-G.; Goh, B.-H.; Lee, L.-H. The potential of Streptomyces as biocontrol agents against the rice blast fungus, Magnaporthe oryzae (Pyricularia oryzae). Front. Microbiol. 2017, 8, 3. [Google Scholar] [CrossRef] [PubMed]
- Zhao, J.; Xue, Q.-h.; Niu, G.-g.; Xue, L.; Shen, G.-h.; Du, J.-z. Extracellular enzyme production and fungal mycelia degradation of antagonistic Streptomyces induced by fungal mycelia preparation of cucurbit plant pathogens. Ann. Microbiol. 2013, 63, 809–812. [Google Scholar] [CrossRef]
- Soltani Nejad, M.; Samandari Najafabadi, N.; Aghighi, S.; Pakina, E.; Zargar, M. Evaluation of phoma sp. biomass as an endophytic fungus for synthesis of extracellular gold nanoparticles with antibacterial and antifungal properties. Molecules 2022, 27, 1181. [Google Scholar] [CrossRef] [PubMed]
- Firouzi, S.; Nikkhah, A.; Aminpanah, H. Rice single cropping or ratooning agro-system: Which one is more environment-friendly? Environ. Sci. Pollut. Res. 2018, 25, 32246–32256. [Google Scholar] [CrossRef]
- Soltani Nejad, M.; Khatami, M.; Shahidi Bonjar, G.H. Extracellular synthesis gold nanotriangles using biomass of Streptomyces microflavus. IET Nanobiotechnol. 2016, 10, 33–38. [Google Scholar] [CrossRef]
- Soltani Nejad, M.; Shahidi Bonjar, G.H.; Khaleghi, N. Biosynthesis of gold nanoparticles using Streptomyces fulvissimus isolate. Nanomed. J. 2015, 2, 153–159. [Google Scholar] [CrossRef]
- Aghighi, S.; Shahidi Bonjar, G.; Rawashdeh, R.; Batayneh, S.; Saadoun, I. First report of antifungal spectra of activity of Iranian Actinomycetes strains against Alternaria solani, Alternaria alternate, Fusarium solani, Phytophthora megasperma, Verticillium dahliae and Saccharomyces cerevisiae. Asian J. Plant Sci. 2004, 3, 463–471. [Google Scholar] [CrossRef]
- Lee, J.Y.; Hwang, B.K. Diversity of antifungal Actinomycetes in various vegetative soils of Korea. Can. J. Microbiol. 2002, 48, 407–417. [Google Scholar] [CrossRef]
- El-Tarabily, K.A.; Sivasithamparam, K. Non-streptomycete actinomycetes as biocontrol agents of soil-borne fungal plant pathogens and as plant growth promoters. Soil Biol. Biochem. 2006, 38, 1505–1520. [Google Scholar] [CrossRef]
- Sadeghian, M.; Shahidi Bonjar, G.H.; Sharifi Sirchi, G.R. Post harvest biological control of apple bitter rot by soil-borne Actinomycetes and molecular identification of the active antagonist. Postharvest. Biol. Technol. 2016, 112, 46–54. [Google Scholar] [CrossRef]
- Davelos, A.L.; Kinkel, L.L.; Samac, D.A. Spatial variation in frequency and intensity of antibiotic interactions among Streptomycetes from prairie soil. Appl. Environ. Microbiol. 2004, 70, 1051–1058. [Google Scholar] [CrossRef] [PubMed]
- Jorjandi, M.; Bonjar, G.; Baghizadeh, A.; Sirchi, G.; Massumi, H.; Baniasadi, F.; Aghighi, S.; Farokhi, P. Biocontrol of Botrytis allii Munn the causal agent of neck rot, the postharvest disease in onion, by use of a new Iranian isolate of Streptomyces. Am. J. Agric. Biol. Sci. 2009, 4, 72–78. [Google Scholar] [CrossRef][Green Version]
- Hassanisaadi, M.; Shahidi Bonjar, G.H.; Hosseinipour, A.; Abdolshahi, R.; Ait Barka, E.; Saadoun, I. Biological control of Pythium aphanidermatum, the causal agent of tomato root rot by two Streptomyces root symbionts. Agronomy 2021, 11, 846. [Google Scholar] [CrossRef]
- Dunne, C.; Moënne-Loccoz, Y.; de Bruijn, F.J.; O’Gara, F. Overproduction of an inducible extracellular serine protease improves biological control of Pythium ultimum by Stenotrophomonas maltophilia strain W81. Microbiology 2000, 146, 2069–2078. [Google Scholar] [CrossRef] [PubMed]
- Rodarte, M.P.; Dias, D.R.; Vilela, D.M.; Schwan, R.F. Proteolytic activities of bacteria, yeasts and filamentous fungi isolated from coffee fruit (Coffea arabica L.). Acta Sci. Agron. 2011, 33, 457–464. [Google Scholar] [CrossRef]
- Soltani Nejad, M.; Bonjar, G.H.S.; Khatami, M.; Amini, A.; Aghighi, S. In vitro and in vivo antifungal properties of silver nanoparticles against Rhizoctonia solani, a common agent of rice sheath blight disease. IET Nanobiotechnol. 2017, 11, 236–240. [Google Scholar] [CrossRef]
- Kazemi, H.; Kamkar, B.; Lakzaei, S.; Badsar, M.; Shahbyki, M. Energy flow analysis for rice production in different geographical regions of Iran. Energy 2015, 84, 390–396. [Google Scholar] [CrossRef]
- Park, D.-S.; Sayler, R.J.; Hong, Y.-G.; Nam, M.-H.; Yang, Y. A method for inoculation and evaluation of rice sheath blight disease. Plant Dis. 2007, 92, 25–29. [Google Scholar] [CrossRef]
- Yadav, S.; Anuradha, G.; Kumar, R.; Vemireddy, L.; Sudhakar, R.; Donempudi, K.; Venkata, D.; Jabeen, F.; Narasimhan, Y.; Marathi, B.; et al. Identification of QTLs and possible candidate genes conferring sheath blight resistance in rice (Oryza sativa L.). SpringerPlus 2015, 4, 175. [Google Scholar] [CrossRef]
- Pereira, P.M.; Santana, F.M.; Van Der Sand, S. Evaluation of Streptomyces spp. strains as potential biocontrol agents for Pyrenophora tritici-repentis. Biocontrol Sci. Technol. 2022, 32, 1095–1106. [Google Scholar] [CrossRef]
- Salla, T.D.; Ramos da Silva, T.; Astarita, L.V.; Santarém, E.R. Streptomyces rhizobacteria modulate the secondary metabolism of Eucalyptus plants. Plant Physiol. Biochem. 2014, 85, 14–20. [Google Scholar] [CrossRef] [PubMed]
- Pacios-Michelena, S.; Aguilar González, C.N.; Alvarez-Perez, O.B.; Rodriguez-Herrera, R.; Chávez-González, M.; Arredondo Valdés, R.; Ascacio Valdés, J.A.; Govea Salas, M.; Ilyina, A. Application of Streptomyces antimicrobial compounds for the control of hpytopathogens. Front. Sustain. Food Syst. 2021, 5, 696518. [Google Scholar] [CrossRef]
- Santos-Beneit, F.; Ceniceros, A.; Nikolaou, A.; Salas, J.A.; Gutierrez-Merino, J. Identification of antimicrobial compounds in two Streptomyces sp. strains isolated from beehives. Front. Microbiol. 2022, 13, 742168. [Google Scholar] [CrossRef]
- Zhang, L.; Liu, Z.; Wang, Y.; Zhang, J.; Wan, S.; Huang, Y.; Yun, T.; Xie, J.; Wang, W. Biocontrol potential of endophytic Streptomyces malaysiensis 8ZJF-21 from medicinal plant against banana Fusarium wilt caused by Fusarium oxysporum f. sp. cubense tropical race 4. Front. Plant Sci. 2022, 13, 874819. [Google Scholar] [CrossRef]
- Dziggel, C.; Schäfer, H.; Wink, M. Tools of pathway reconstruction and production of economically relevant plant secondary metabolites in recombinant microorganisms. Biotechnol. J. 2017, 12, 1600145. [Google Scholar] [CrossRef]
- Peng, D.; Li, S.; Wang, J.; Chen, C.; Zhou, M. Integrated biological and chemical control of rice sheath blight by Bacillus subtilis NJ-18 and jinggangmycin. Pest Manag. Sci. 2014, 70, 258–263. [Google Scholar] [CrossRef]
- Santiago, T.R.; Grabowski, C.; Rossato, M.; Romeiro, R.S.; Mizubuti, E.S.G. Biological control of eucalyptus bacterial wilt with rhizobacteria. Biol. Control 2015, 80, 14–22. [Google Scholar] [CrossRef]
- Li, Q.; Ning, P.; Zheng, L.; Huang, J.; Li, G.; Hsiang, T. Fumigant activity of volatiles of Streptomyces globisporus JK-1 against Penicillium italicum on Citrus microcarpa. Postharvest. Biol. Technol. 2010, 58, 157–165. [Google Scholar] [CrossRef]
- Gao, F.; Wu, Y.; Wang, M. Identification and antifungal activity of an Actinomycetes strain against Alternaria spp. Span. J. Agric. Res. 2014, 12, 1158–1165. [Google Scholar] [CrossRef]
- Gao, Y.; Zeng, X.D.; Ren, B.; Zeng, J.R.; Xu, T.; Yang, Y.Z.; Hu, X.C.; Zhu, Z.Y.; Shi, L.M.; Zhou, G.Y.; et al. Antagonistic activity against rice blast disease and elicitation of host-defence response capability of an endophytic Streptomyces albidoflavus OsiLf-2. Plant Pathol. 2020, 69, 259–271. [Google Scholar] [CrossRef]
- AlAli, H.A.; Khalifa, A.; Almalki, M. Plant growth-promoting bacterium from non-agricultural soil Improves okra plant growth. Agriculture 2022, 12, 873. [Google Scholar] [CrossRef]
- Olanrewaju, O.S.; Babalola, O.O. Streptomyces: Implications and interactions in plant growth promotion. Appl. Microbiol. Biotechnol. 2019, 103, 1179–1188. [Google Scholar] [CrossRef] [PubMed]
- Rachid, L. Biological Control of Plant Pathogens: A Global Perspective. Microorganisms 2022, 10, 596. [Google Scholar] [CrossRef]
- Hu, D.; Li, S.; Li, Y.; Peng, J.; Wei, X.; Ma, J.; Zhang, C.; Jia, N.; Wang, E.; Wang, Z. Streptomyces sp. strain TOR3209: A rhizosphere bacterium promoting growth of tomato by affecting the rhizosphere microbial community. Sci. Rep. 2020, 10, 20132. [Google Scholar] [CrossRef] [PubMed]

| Treatments | RLH% | Shoot Fresh Weight (g) | Shoot Dry Weight (g) | Root Fresh Weight (g) | Root Dry Wight (g) | Shoot Length (cm) | Root Length (cm) |
|---|---|---|---|---|---|---|---|
| Control | _ | 11.83 * A | 5.57 B | 6.53 AB | 3.51 AB | 30.52 AB | 12.40 BC |
| Pathogen | 95% | 4.57 D | 2.48 DC | 2.28 D | 0.96 D | 10.18 D | 5.37 D |
| Isolate No. 5 | _ | 11.23 AB | 7.43 ABC | 6.84 BC | 3.54 AB | 28.54 B | 14.41 BC |
| Isolate G | _ | 11.76 A | 8.75 AB | 7.89 AB | 4.61 A | 32.27 A | 20.26 A |
| Isolate U | _ | 11.19 ABC | 6.24 AB | 6.48 CD | 3.18 ABC | 22.11 BC | 10.61 BC |
| Pathogen+ G | 42% | 11.12 BC | 6.89 AB | 7.61 D | 4.35 CD | 21.83 BC | 18.20 AC |
| Pathogen + No. 5 | 53% | 11.07 BC | 6.17 AB | 6.73 AD | 3.21 BC | 19.69 BC | 19.12 A |
| Pathogen+ U | 75% | 8.43 CD | 4.26 BC | 5.39 D | 2.64 CD | 18.18 BCD | 9.76 CD |
| SE± | 0.91 | 0.83 | 0.86 | 0.57 | 1.68 | 1.25 |
Publisher’s Note: MDPI stays neutral with regard to jurisdictional claims in published maps and institutional affiliations. |
© 2022 by the authors. Licensee MDPI, Basel, Switzerland. This article is an open access article distributed under the terms and conditions of the Creative Commons Attribution (CC BY) license (https://creativecommons.org/licenses/by/4.0/).
Share and Cite
Soltani Nejad, M.; Samandari Najafabadi, N.; Aghighi, S.; Shahidi Bonjar, A.H.; Murtazova, K.M.-S.; Nakhaev, M.R.; Zargar, M. Investigating the Potential of Streptomyces spp. in Suppression of Rhizoctonia solani (AG1-IA) Causing Rice Sheath Blight Disease in Northern Iran. Agronomy 2022, 12, 2292. https://doi.org/10.3390/agronomy12102292
Soltani Nejad M, Samandari Najafabadi N, Aghighi S, Shahidi Bonjar AH, Murtazova KM-S, Nakhaev MR, Zargar M. Investigating the Potential of Streptomyces spp. in Suppression of Rhizoctonia solani (AG1-IA) Causing Rice Sheath Blight Disease in Northern Iran. Agronomy. 2022; 12(10):2292. https://doi.org/10.3390/agronomy12102292
Chicago/Turabian StyleSoltani Nejad, Meysam, Neda Samandari Najafabadi, Sonia Aghighi, Amir Hashem Shahidi Bonjar, Kheda Magomed-Salihovna Murtazova, Magomed Ramzanovich Nakhaev, and Meisam Zargar. 2022. "Investigating the Potential of Streptomyces spp. in Suppression of Rhizoctonia solani (AG1-IA) Causing Rice Sheath Blight Disease in Northern Iran" Agronomy 12, no. 10: 2292. https://doi.org/10.3390/agronomy12102292
APA StyleSoltani Nejad, M., Samandari Najafabadi, N., Aghighi, S., Shahidi Bonjar, A. H., Murtazova, K. M.-S., Nakhaev, M. R., & Zargar, M. (2022). Investigating the Potential of Streptomyces spp. in Suppression of Rhizoctonia solani (AG1-IA) Causing Rice Sheath Blight Disease in Northern Iran. Agronomy, 12(10), 2292. https://doi.org/10.3390/agronomy12102292

